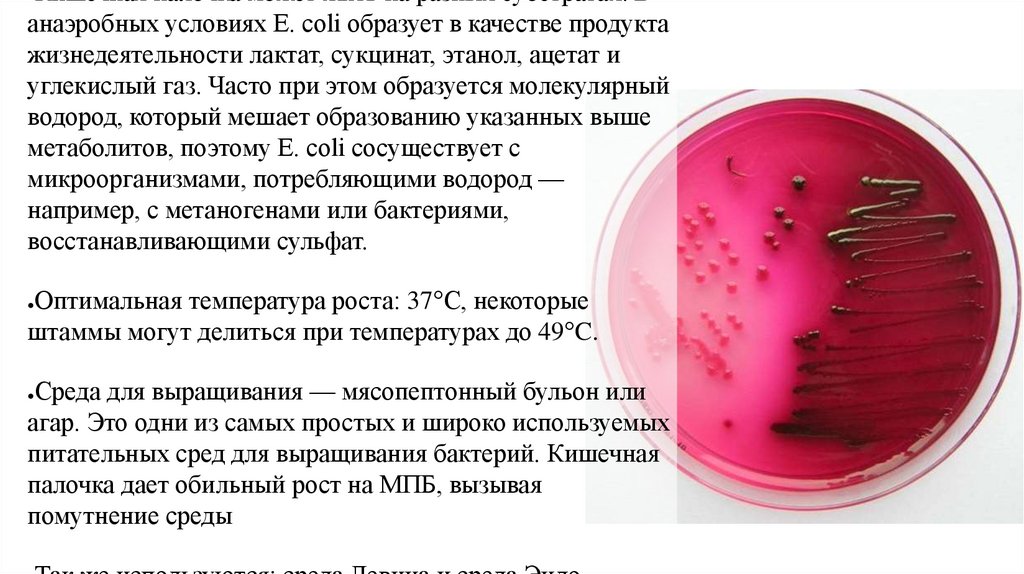

Similar presentations:
Кишечная палочка
1.
Кишечная палочкаEscherichia coli
2.
E.coli - это условно-патогенная бактерия, которая обитает внижних отделах кишечника теплокровных животных, включая
человека. Она является одним из наиболее распространённых
представителей микрофлоры кишечника - в норме составляет до
1%, а также участвует в синтезе витаминов В и К и способствует
усвоению кальция и железа. Однако некоторые штаммы E. coli
могут вызывать серьезные заболевания.
E. coli была описана немецким педиатром и бактериологом
Теодором Эшерихом в 1885 году. В настоящее время кишечную
палочку относят к роду эшерихий (Escherichia), названному в
честь Теодора Эшериха семейства энтеробактерий.
3.
Форма и размер: E. coli имеет форму палочек сОписание
и характеристика
закруглёнными концами,
размером 0,4—0,8
×
1—3 мкм. Объём клетки составляет около
0,6—0,7 мкм³.
Грамотрицательная бактерия: Клетки имеют
внешнюю мембрану, которая содержит
липополисахариды.
Факультативный анаэроб: Может жить как в
присутствии кислорода, так и без него.
Не образует эндоспор: Споры не формируются
в условиях, неблагоприятных для роста.
Некоторые штаммы имеют жгутики и
способны передвигаться. Жгутики
расположены перитрихиально.
4.
Кишечная палочка может жить на разных субстратах. Ванаэробных условиях E. coli образует в качестве продукта
жизнедеятельности лактат, сукцинат, этанол, ацетат и
углекислый газ. Часто при этом образуется молекулярный
водород, который мешает образованию указанных выше
метаболитов, поэтому E. coli сосуществует с
микроорганизмами, потребляющими водород —
например, с метаногенами или бактериями,
восстанавливающими сульфат.
Оптимальная температура роста: 37°C, некоторые
штаммы могут делиться при температурах до 49°C.
Среда для выращивания — мясопептонный бульон или
агар. Это одни из самых простых и широко используемых
питательных сред для выращивания бактерий. Кишечная
палочка дает обильный рост на МПБ, вызывая
помутнение среды
5.
Кишечная палочка (Escherichia coli) играет важную роль внормальной микрофлоре животных, выполняя несколько ключевых
функций:
Роль в организме
Защитная
Пищеварительная
Иммуномоделирующая
Синтез витаминов и аминокислот
Физиологическая
Однако при нарушении баланса микрофлоры кишечника или при
попадании патогенных штаммов E. coli в организм, она может стать
6.
Патогенные штаммыПатогенные штаммы эшерихий могут
вызывать различные заболевания:
Энтероколит
Инфекции мочеполовой системы
Пневмония
Сепсис
7.
КолибактериозКолибактериоз, или эшерихиоз, является острой инфекционной болезнью
молодняка всех видов сельскохозяйственных животных. Это заболевание
вызывается патогенной кишечной палочкой (Escherichia coli) и
характеризуется главным образом диареей, которая наносит значительный
ущерб животноводству
Заражение колибактериозом происходит в первые 3–7 суток после
рождения у телят, однако может встречаться и у других видов животных.
Основные пути заражения включают:
Алиментарный путь: Через инфицированные окружающие предметы,
молозиво, молочную посуду, воздух, руки и спецодежду обслуживающего
8.
Симптомы колибактериоза у молодняка: диарея, снижение аппетита,вялость, потеря веса, обезвоживание. В тяжелых случаях может
наблюдаться судороги и кома. У взрослых животных симптомы могут быть
менее выраженными, но могут включать снижение продуктивности,
вялость, потерю аппетита.
Диагноз ставится на основании комплексной диагностики, включая
клинический осмотр животного, сбор анамнеза, проведение лабораторных
исследований, в том числе бактериологический посев. Это позволяет
определить наличие патогенных штаммов E. coli и подтвердить диагноз.
Лечение колибактериоза включает применение антибиотиков, которые
подбираются с учетом чувствительности выделенных штаммов E. coli.
Также может потребоваться симптоматическое лечение, направленное на
устранение обезвоживания, восстановление электролитного баланса и
поддержку функции органов.
9.
ПрофилактикаСоблюдение правил содержания и кормления
Гигиена родов и выкармливания молодняка
Секционное содержание новорожденных
Вакцинация
Дезинфекция помещений и оборудования
Изоляция больных животных и карантин

medicine
medicine








